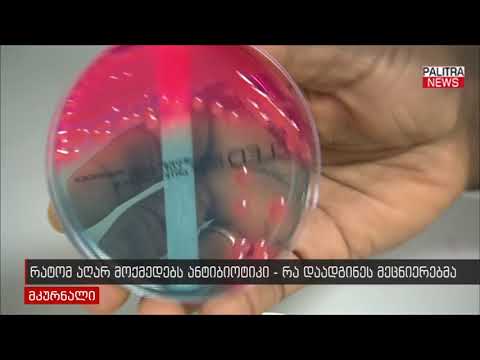
რატომ აღარ მოქმედებს ანტიბიოტიკი - რა დაადგინეს მეცნიერებმა

რატომ აღარ დაძვრებიან ბავშვები ხეებზე
20.04.2022
17:38
რატომ აღარ დაძვრებიან ბავშვები ხეებზე და როგორ აფერხებს პატარების ნევროლოგიურ განვითარებას თანამედროვე ცხოვრების წესი? - ქეთი ასათიანის რუბრიკაში #დიეტა+ ეწვიეთ ტელეკომპანია "იმედის" ოფიციალურ საიტს https://www.imedi.ge/ge/shows/34/imed... გადაცემის ოფიციალური Facebook გვერდი / imedisdghe © Teleimedi LLC 2022
მსგავსი ვიდეოები

გიგა კვენეტაძის კლიპის პრემიერა
Music Box

რატომ აღარ უწევენ რეკომენდაციას პედიატრები მანანის ფაფას ? -...
TV IMEDI

რატომ აღარ არის ნანკა კალატოზიშვილი "ცეკვავენ ვარსკვლავების“...
Music Box

რატომ აღარ ჩანს ქართულ შოუბიზნესში ხშირად თამთა ჭელიძე
Music Box

#ახალიდღე რატომ აღარ თოვს თბილისში? - მითები და რეალობა გლობ...
პირველი არხი Georgian Public Broadcaster
რატომ აღარ მოქმედებს ანტიბიოტიკი - რა დაადგინეს მეცნიერებმა
PalitraNews

რატომ აღარ იღებ ვიდეობს? ცოცხალი ხარ?!
TheVNProject

რატომ აღარ ჩანს ნანა ნებიერიძე ტელეეკრანებზე და რა ბიზნესითა...
Music Box







